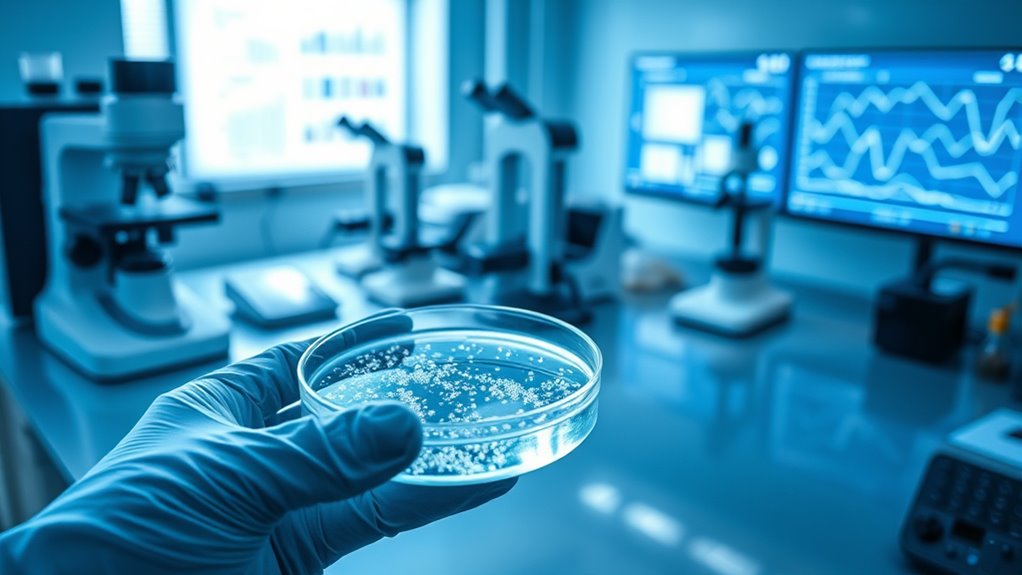
long term toxicity evaluation methods
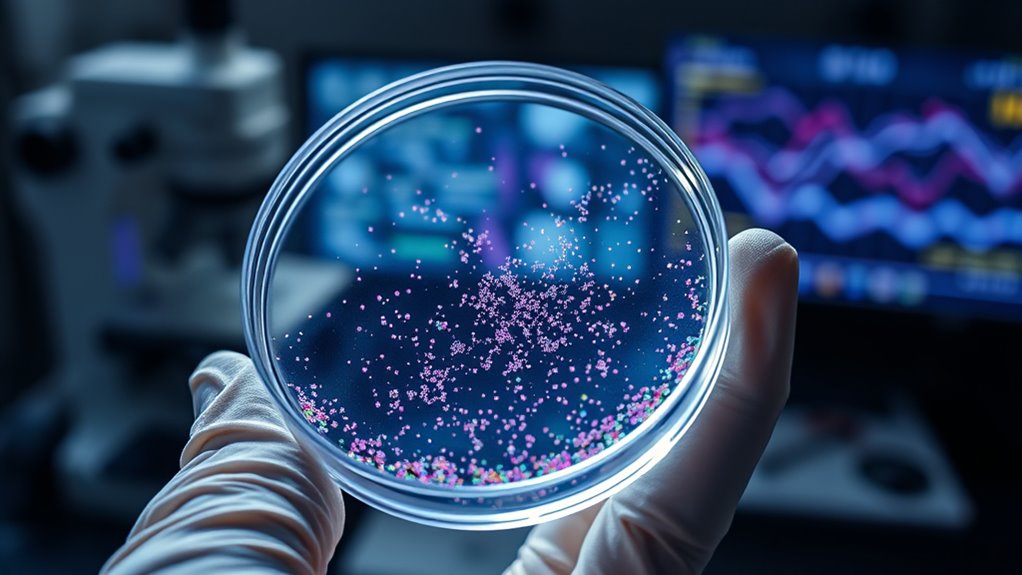
surface modification enhances safety

Nanotoxicology examines the long-term health and environmental impacts of medical nanoparticles. It involves studying how these particles are absorbed, accumulated, and potentially cause damage via mechanisms like oxidative stress and cellular toxicity. To guarantee safety, scientists use in vivo and in vitro assessments, focusing on long-term effects and bioaccumulation risks. Regulatory frameworks and safety standards guide development. To understand how these evaluations inform safer nanomedicine practices, keep exploring the ongoing research and strategies included in this field.
Key Takeaways
- Long-term nanotoxicology assessments include in vivo and in vitro studies to monitor delayed or subtle toxic effects over extended periods.
- Evaluating nanoparticle biodegradation and bioaccumulation helps determine persistence and potential long-term biological impacts.
- Monitoring oxidative stress, inflammation, and cellular damage provides insights into chronic toxicity mechanisms of medical nanoparticles.
- Standardized testing protocols and environmental impact evaluations are essential for consistent long-term safety assessments.
- Incorporating long-term safety data into regulatory frameworks ensures responsible development of nanomedicine applications.

Eldoncard INC Blood Type Test, 1 Pack
Quick Results: Learn your blood type in just a couple of minutes with this easy-to-use testing kit
As an affiliate, we earn on qualifying purchases.
As an affiliate, we earn on qualifying purchases.
Understanding Nanoparticles in Medicine

Nanoparticles have revolutionized medicine by enabling targeted drug delivery and improved diagnostics. To create effective nanoparticles, you focus on nanoparticle synthesis, which involves carefully controlling size, shape, and composition. This process determines how the particles interact within the body. One key factor is surface charge, which influences stability, cellular uptake, and biodistribution. Positively charged particles tend to bind more readily to cell membranes, improving delivery efficiency, but may also increase toxicity. Conversely, negatively charged or neutral particles often show better biocompatibility. Understanding how to manipulate synthesis methods and surface charge allows you to design nanoparticles tailored for specific medical applications, ensuring they reach their targets effectively while minimizing unwanted interactions. For example, colorful presentation can encourage exploration and enjoyment, which is important in designing biocompatible materials. This foundational knowledge is *vital* for advancing safe and effective nanomedicine.

Targeted Delivery of Pesticides Using Biodegradable Polymeric Nanoparticles (SpringerBriefs in Molecular Science)
As an affiliate, we earn on qualifying purchases.
As an affiliate, we earn on qualifying purchases.
Potential Health Risks of Medical Nanoparticles

While nanotechnology offers promising medical benefits, it also poses potential health risks that warrant careful consideration. You should be aware of possible adverse effects, including:
Nanotechnology’s benefits come with health risks that require careful evaluation and regulation.
- Environmental impact from nanoparticle accumulation in ecosystems
- Long-term health concerns, such as toxicity or immune responses
- Ethical considerations surrounding patient safety and informed consent
These risks highlight the need for thorough evaluation of nanoparticle safety before widespread use. You must consider how nanoparticles might persist in the environment, potentially affecting wildlife and human populations. Additionally, ethical questions arise about transparency and risk communication. As you explore these risks, remember that responsible development and regulation are essential to minimize harm. Ensuring safety and addressing ethical concerns will be key to harnessing nanotechnology’s benefits without unintended consequences. Attention in creative practice can help researchers stay focused on safety protocols and ethical standards throughout development.
long-term nanoparticle toxicity assessment tools
As an affiliate, we earn on qualifying purchases.
As an affiliate, we earn on qualifying purchases.
Mechanisms of Nanoparticle Toxicity

Understanding how nanoparticles cause toxicity is essential for evaluating their safety. When you introduce nanoparticles into the body, they can be taken up by cells through processes like endocytosis, leading to cellular uptake. Once inside, these particles may generate oxidative stress by producing reactive oxygen species (ROS), which damage cellular components like DNA, proteins, and lipids. This oxidative stress triggers inflammatory responses and can impair cell function or cause apoptosis. The size, shape, and surface properties of nanoparticles influence their ability to enter cells and induce toxicity. By understanding these mechanisms, you can better predict long-term health risks and design safer nanomaterials. Recognizing how oxidative stress and cellular uptake interact helps in developing strategies to mitigate nanoparticle-induced damage. cellular uptake plays a crucial role in determining nanoparticle toxicity levels.
nanoparticle bioaccumulation monitoring devices
As an affiliate, we earn on qualifying purchases.
As an affiliate, we earn on qualifying purchases.
Methods for Long‑Term Toxicity Assessment
Evaluating the long-term toxicity of nanomaterials requires a combination of in vivo and in vitro methods that track their effects over extended periods. You should consider studying biodegradation pathways to understand how nanoparticles break down over time and their potential accumulation. Monitoring environmental impact is essential, as nanoparticles may persist or transform in ecosystems, affecting organisms long-term. Techniques include chronic animal studies, cell culture assays, and environmental simulations. These approaches help detect subtle, delayed toxic effects and assess persistence. Key aspects to focus on are:
- Tracking biodegradation pathways to predict nanoparticle persistence
- Evaluating long-term bioaccumulation risks
- Assessing environmental impact over time
- Incorporating Gold IRA insights to ensure comprehensive safety evaluations
Regulatory Frameworks and Safety Standards

Regulatory agencies worldwide are establishing guidelines to guarantee nanomaterials are safe for use. You need to understand how standardized testing protocols and risk assessment procedures help identify potential hazards. These frameworks are essential for balancing innovation with public health protection. Additionally, consistent testing standards ensure comparability of safety data across different studies and products.
International Regulatory Agencies
Have you ever wondered how safety standards for nanomaterials are established across countries? International regulatory agencies play a vital role in this process. They foster *international collaboration*, which helps harmonize policies and reduce discrepancies. These agencies actively participate in *policy development* to create thorough safety frameworks.
You should be aware that:
- Agencies like the FDA, EMA, and WHO work together to share data and best practices.
- They develop guidelines to ensure consistent safety assessments worldwide.
- Cross-border initiatives facilitate the adoption of uniform regulations for nanomaterials.
This cooperation helps prevent safety gaps and promotes responsible innovation in nanomedicine. Your understanding of these agencies’ roles highlights the importance of unified efforts in safeguarding public health against long-term nanoparticle exposure.
Standardization of Testing Protocols
To guarantee the safe use of nanomaterials, establishing standardized testing protocols is essential, as these frameworks provide clear guidelines for evaluating their health and environmental impacts. Standardized protocols help ensure consistency across studies, but reproducibility challenges remain due to variations in testing methods and nanomaterial properties. Addressing these challenges requires harmonized procedures that minimize discrepancies and improve data reliability. Implementing such protocols enables you to compare results accurately and build trustworthy safety standards. The table below summarizes key aspects of standardized testing protocols:
| Aspect | Challenge/Consideration |
|---|---|
| Protocols | Need for harmonization to reduce variability |
| Reproducibility | Ensuring consistent results across labs |
| Validation | Confirming tests accurately reflect real-world effects |
| Regulations | Incorporation into regulatory frameworks |
Risk Assessment Procedures
How do we guarantee nanomaterials are safe for both people and the environment? Risk assessment procedures are essential, involving regulatory frameworks and safety standards that evaluate potential hazards. You need to take into account:
- The environmental impact, including how nanoparticles may accumulate or disperse in ecosystems
- Manufacturing challenges, such as reproducibility and controlling nanoparticle properties
- Long-term effects on human health and ecosystems, requiring thorough testing protocols
Case Studies of Nanoparticle-Related Risks

Numerous case studies highlight the potential risks associated with nanoparticle exposure, revealing that these tiny materials can pose significant health and environmental hazards. These incidents often spark ethical dilemmas, forcing you to contemplate the balance between innovation and safety. Public perception plays a critical role, as reports of nanoparticle toxicity can fuel fear and skepticism, even when scientific evidence is inconclusive. For example, accidental releases during manufacturing or disposal have led to localized environmental contamination, raising questions about responsibility and regulation. These cases emphasize the importance of transparent risk communication and thorough long-term studies. Additionally, understanding best practices for nanoparticle safety is essential for minimizing risks and ensuring responsible development. As you evaluate nanoparticle applications, understanding these risks helps you appreciate the complex interplay between technological advancement, ethical considerations, and societal trust.
Strategies for Safer Nanoparticle Design
To make nanoparticles safer, you can apply surface modification techniques that diminish toxicity and improve interactions with biological systems. Enhancing biocompatibility ensures these particles are less likely to cause adverse effects in the body. Additionally, employing controlled release methods allows you to manage nanoparticle delivery, minimizing potential risks while maximizing benefits. Incorporating trendy dog sweaters into nanoparticle design may also promote user acceptance and comfort in biomedical applications.
Surface Modification Techniques
Surface modification techniques are essential strategies for designing safer nanoparticles by altering their interactions with biological systems. By adjusting surface chemistry through various coating techniques, you can reduce toxicity, improve stability, and enhance targeting capabilities. These methods help prevent unwanted immune responses and minimize long-term accumulation. Key approaches include applying biocompatible coatings, functionalizing surfaces with specific molecules, and controlling charge and hydrophobicity.
- Using PEGylation to create a stealth effect that evades immune detection
- Coating with silica or polymers to enhance stability and reduce reactivity
- Functionalizing surfaces with ligands for targeted delivery and minimized off-target effects
Biocompatibility Enhancements
Enhancing the biocompatibility of nanoparticles is essential for minimizing adverse biological responses and ensuring safe medical applications. One effective strategy is applying surface coatings that reduce toxicity and improve compatibility with biological systems. These coatings, such as polyethylene glycol (PEG) or zwitterionic materials, create a barrier that prevents protein adsorption and reduces immune recognition. By carefully selecting surface coating materials, you can enhance biocompatibility, decrease inflammation, and extend circulation time in the body. This approach not only minimizes potential side effects but also promotes better targeting and integration with tissues. Biocompatibility enhancement through surface coating is a critical step in designing safer nanoparticles, ensuring they perform their intended functions without eliciting harmful biological reactions.
Controlled Release Methods
Implementing controlled release methods is essential for designing safer and more effective nanoparticles. These strategies enhance targeted delivery, reduce side effects, and improve therapeutic outcomes. Using biodegradable coatings, you can guarantee the nanoparticles break down safely after delivering their payload, minimizing long-term toxicity. Consider the following approaches:
- Surface modifications that respond to environmental triggers for precise drug release
- Layered biodegradable coatings that control release rates and protect active agents
- Encapsulation techniques to prevent premature release and improve stability
Future Directions in Nanotoxicology Research

As nanotoxicology continues to evolve, future research will focus on developing more accurate assessment tools and standardized testing protocols to better predict nanomaterial hazards. This progress is essential for facilitating market adoption, as industry stakeholders need reliable safety data to move forward confidently. Additionally, addressing ethical considerations becomes increasingly important as nanomaterials enter medical applications and consumer products. You’ll see efforts directed toward harmonizing testing methods across laboratories, ensuring consistent results and regulatory acceptance. Researchers will also explore long-term environmental impacts and bioaccumulation, guiding responsible innovation. The integration of remote hackathons can foster collaborative development of new evaluation techniques and safety standards among global experts. By refining risk assessment frameworks, nanotoxicology can better support safe development and public trust while balancing technological advancement with societal and ethical responsibilities.
Integrating Safety Assessments Into Medical Innovation

Advancements in nanotoxicology are paving the way for safe and effective medical innovations, but integrating thorough safety evaluations remains a key challenge. To ensure responsible progress, you need to contemplate how safety evaluations impact various aspects of development. Focus on:
- Evaluating environmental impact to prevent nanoparticle pollution.
- Promoting manufacturing sustainability to reduce waste and energy use.
- Establishing standardized protocols that balance innovation with safety.
- Incorporate risk assessment techniques to identify potential hazards early in the development process.
Frequently Asked Questions
How Do Long-Term Effects of Nanoparticles Differ From Short-Term Toxicity?
You’ll notice that long-term effects of nanoparticles differ from short-term toxicity through chronic accumulation and delayed responses. While short-term toxicity shows immediate symptoms, long-term effects develop gradually, often due to particles building up in your body over time. This can lead to subtle health issues that may not appear right away, requiring ongoing monitoring to understand the full impact of prolonged exposure to nanoparticles.
Are There Specific Populations More Vulnerable to Nanoparticle Exposure?
You might think everyone’s equally vulnerable, but certain demographics and genetic predispositions make some people more at risk of nanoparticle exposure. Children, pregnant women, and the elderly often have less developed or compromised immune systems, increasing their susceptibility. Additionally, individuals with specific genetic traits may process or react to nanoparticles differently, heightening their vulnerability. Recognizing these groups helps you prioritize safety and tailor protective measures effectively.
What Are the Economic Impacts of Implementing Strict Nanotoxicology Regulations?
Implementing strict nanotoxicology regulations impacts your operations through increased costs for regulatory compliance and safety measures. However, a thorough cost-benefit analysis shows that these regulations can prevent costly health issues and product recalls down the line. While initial expenses rise, you benefit from enhanced safety, consumer trust, and long-term sustainability. Overall, investing in strict regulations can safeguard your reputation and reduce potential liabilities, making it a wise strategic choice.
How Do Environmental Factors Influence Nanoparticle Persistence and Toxicity?
Did you know that environmental factors directly impact how long nanoparticles stay in ecosystems and how toxic they become? Environmental interactions, such as pH levels, temperature, and organic matter, influence persistence mechanisms, making nanoparticles more or less stable over time. These factors can enhance or reduce toxicity, affecting aquatic life and soil health. Understanding these influences helps predict long-term environmental risks and develop safer nanomaterials.
Can Current Medical Nanotechnology Be Fully Adapted for Personalized Medicine?
You can modify current medical nanotechnology for personalized therapy by leveraging nanoparticle targeting to customize treatments. By designing nanoparticles tailored to individual patient profiles, you enhance precision and efficacy. Advances in nanomedicine enable you to deliver drugs directly to specific cells or tissues, reducing side effects. While challenges remain, ongoing research ensures that personalized nanotherapy becomes increasingly feasible, making it a promising approach for tailored healthcare solutions.
Conclusion
As you explore nanotoxicology, remember that over 20% of medical nanoparticles tested still show long-term toxicity concerns. This highlights the urgency of thorough safety assessments before widespread use. You can play a essential role by staying informed and advocating for rigorous testing standards. By understanding the potential risks and supporting safer design strategies, you help guarantee that medical advancements benefit patients without compromising health. Your vigilance is key to responsible nanomedicine development.